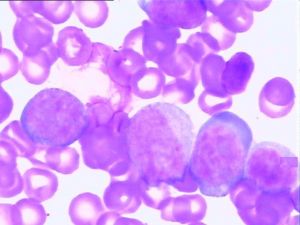
先天性再生障礙性貧血

流行病學
 先天性再生障礙性貧血病理圖
先天性再生障礙性貧血病理圖先天性再生障礙性貧血發生於嬰幼兒,多數患兒出生後2周~2年後發病,絕大多數(超過90%)患兒在1歲內確診,先天性再生障礙性貧血男女患者之比約為1.1∶1。
病因:
先天性再生障礙性貧血偶見於同胞兄妹中,提示先天性再生障礙性貧血為遺傳性疾病。僅不足10%患者有家族史 其餘多數患者呈散發性。1/3患者為常染色體顯性遺傳,其餘為隱性遺傳。通過連鎖分析揭示DBA的遺傳基因位點至少有3個,其中2個位點已確定,分別為19q13.2和8p23.3-p22。已在19q13.2區克隆出相關的致病基因,為核糖體蛋白S19(ribosomal protein S19,RPS19)基因。序列分析發現約25% DBA患者具有RPS19突變。
發病機制
 先天性再生障礙性貧血病理圖
先天性再生障礙性貧血病理圖研究證實DBA患者並不存在SCL基因與GATA基因表達及其蛋白產物結構異常,但其E蛋白表達顯著低下,而KL體外可以糾正這一缺陷,因此從分子水平上揭示KL可能通過促進SCL/E蛋白異源二聚體形成發揮其刺激DBA紅系造血作用。E蛋白異常與DBA紅系造血缺陷間關係有待更進一步研究。
現已明確,DBA患者EPO與EPO-R基因表達及其蛋白質結構均無異常,亦不存在抗EPO-R抗體,但尚不能完全除外DBA存在EPO與EPO-R結合後信號傳遞異常。與同等貧血程度的其他良性貧血(如缺鐵性貧血等)患者比較,DBA患者血清EPO水平升高更為顯著,此變化對於保護體內殘存的紅系祖細胞避免過多過快凋亡可能具有重要的生理學意義。
臨床表現
淋巴細胞病理圖
淋巴細胞病理圖(一)先天性純紅再障(diamond-blackfan貧血)90%於初生到1歲內起病,罕有2歲以後發病者,遺傳規律尚不清,有家族性。患兒生長發育遲緩,少數也有輕度先天性畸形,如拇指畸形,和Fanconi貧血不同很少伴發惡性疾病。患者紅系祖細胞不但數量缺乏,並且質有異常。HbF增多,胎兒膜抗原i持續存在,嘌呤解救途徑酶活性增高,說明核酸合成有缺陷。患者淋巴細胞在體外可抑制正常紅系祖細胞的生長。20%病例可自發緩解,60%患者對腎上腺皮質激素有效,無效者亦可做骨髓移植。
(二)急性獲得性純紅再障在慢性溶血性貧血的病程中發生病毒感染,特別是人類微小病毒(parvovirus)B19感染,可選擇性抑制紅系祖細胞,發生急性純紅再障,又稱溶血性貧血的再生障礙性危象;某些病例在病毒感染後發生造血功能暫時停頓,導致全血細胞減少,骨髓中出現巨原紅細胞,又稱急性造血停滯。急性純紅再障也可發生在1~4歲小兒,數周后自愈,並無感染因素,稱兒童暫時性幼紅細胞減少症。急性純紅再障尚見於病毒性肝炎和某些藥物誘發,如苯妥因、硫唑嘌呤、氯黴素、異煙肼和普魯卡因胺等,停藥後大多數病例會完全恢復。
(三)慢性獲得性純紅再障主要見於成人。50%患者伴有胸腺瘤,僅5%胸腺瘤患者有純紅再障;這些胸腺瘤多數系良性,70%為紡錘細胞型,少數為惡性;女性多見(女∶男為3~4.5∶1)。少數尚可繼發於某些自身免疫性疾病如系統性紅斑狼瘡和類風濕關節炎,及某些腫瘤如慢性淋巴細胞白血病、慢性粒細胞白血病、淋巴瘤、免疫母細胞淋巴結病、膽道腺癌、甲狀腺癌、支氣管肺癌及乳腺癌等。原因不明者稱原發性獲得性純紅再障,系多種免疫機制引起幼紅細胞生成抑制,患者血清中存在抗幼紅細胞抗體,抗紅細胞生成素抗體或具有抑制性T淋巴細胞等。患者常伴多種免疫學異常如免疫球蛋白增高或降低、單株免疫球蛋白及血清多種抗體陽性,如冷凝集素、冷溶血素、嗜異抗體、抗核抗體等。抗人球蛋白試驗等陽性。個別患者可伴多種內分泌腺功能減低。不伴胸腺瘤的純紅再障多見於男性(男∶女為2∶1)。
併發症
1.先天性純紅細胞再生障礙性貧血患者易並發多種惡性腫瘤 文獻報導的先天性純紅細胞再生障礙性貧血患者480餘例,其中12例於確診後2~43年並發惡性腫瘤,其中急性髓細胞白血病(AML)6例,急性淋巴細胞白血病(ALL)1例,霍奇金病(HD)2例,骨髓增生異常綜合徵(MDS)2例及肝細胞癌1例。
2.長期套用激素治療者可合併發育障礙及繼發感染。
3.病情進展可導致心力衰竭,晚期因輸血過多可繼發血色病,或心源性肝硬化。
診斷
 白細胞病理圖
白細胞病理圖鑑別診斷:
應注意與Fanconi貧血,兒童一過性原始紅細胞缺乏症(TEC) 慢性溶血性貧血並發B19微小病毒感染 Pearson綜合徵及軟骨毛髮發育不良綜合徵相鑑別,其中先天性純紅細胞再生障礙性貧血與FA鑑別診斷尤為重要。
實驗室檢查:
1.外周血象 呈正細胞正色素性貧血,血紅蛋白10~90g/L,網織紅細胞絕對值減少,嬰幼兒患者一般不伴有外周血白細胞及血小板減少。繼發脾功能亢進可導致全血細胞減少,且有巨幼樣變。
2.骨髓象 增生良好,但紅系顯著減少,其他骨髓細胞均正常。
3.紅細胞存活時間正常。
4.血清鐵及血清鐵飽和度增加,胎兒血紅蛋白增加,i抗原持續存在。
5.血膽紅素和糞膽原排泄正常。
其它輔助檢查:
根據病情、臨床表現、症狀、體徵選擇做心電圖、B超、X線等檢查。
治療及預後
 造血幹細胞結構圖
造血幹細胞結構圖1.腎上腺皮質激素類藥物 約75%患者對腎上腺皮質激素治療有反應,但僅少數患者可獲持續性緩解,超過80%有效患者成為腎上腺皮質激素依賴者。臨床上潑尼松治療先天性純紅細胞再生障礙性貧血的推薦劑量為2mg/(kg•d) 連續1個月以上 此後根據療效反應來調整潑尼松劑量與療程,無效者可試驗性套用大劑量甲潑尼龍(HDMP),100mg/(kg•d)靜脈輸注,連續3天,以後逐漸減量。有報導先天性純紅細胞再生障礙性貧血患者,7例中9例經甲潑尼龍(HDMP)治療後,無需維持劑量潑尼松而獲持久療效,但鑒於甲潑尼龍(HDMP)毒副作用明顯,臨床上對本療法應持慎重態度。有學者報導改用口服甲潑尼龍(HDMP)可減輕其毒副作用。
2.HGFs 已有紅細胞生成素 (rhEPO),rhIL-3及rh莫拉司亭(GM-CSF)單用,聯合或序貫治療先天性純紅細胞再生障礙性貧血,僅rhIL-3對部分患者有效。Bastion等套用rhIL-3治療先天性純紅細胞再生障礙性貧血患者25例,劑量由2.5μg /(kg• d)逐漸遞增至10μg/(kg•d),連續8~12周,其中13例患者獲得持久性療效。
3.異基因骨髓移植(allo-BMT) allo-BMT已成功用於難治性先天性純紅細胞再生障礙性貧血患者治療。Greinix等對依賴輸血先天性純紅細胞再生障礙性貧血患者4例實施HLA匹配同胞供體的allo-BMT,除1例早期死於肺臟合併症外 其餘3例於allo-BMT後分別存活3.0,7.4及10.6年 Kamofsky行為評分顯示此3例患者生存質量良好。國際骨髓移植登記處(IBMTR)報導先天性純紅細胞再生障礙性貧血患者10例allo-BMT療效,8例接受HIL匹配同胞供體allo-BMT,其中6例已存活5~87個月,2年存活率高達72.0%;而另2例接受非HLA匹配供體者於allo-BMT後2周內死亡。最近有報導臍血造血幹細胞移植治療輸血依賴先天性純紅細胞再生障礙性貧血患者獲成功。
4.其他 有人曾試用雄激素,但更須注意對患兒發育的影響。有人試用環孢素(環孢素A),使血細胞比容增加,但不能持久。
新近有報告對1例因長期輸血導致血色病的先天性純紅細胞再生障礙性貧血患者套用重組人生長激素(rhGH)治療後,其生長速度明顯加快。
預後:
不同遺傳方式、多變的臨床表現以及各異的體外生物學反應等提示先天性再生障礙性貧血可能為不同病因所致的一組異質性疾患。患者存活期及存活質量取決於其臨床療效反應,為尋求療效更為確切的治療手段(如基因治療等),應進一步深入研究先天性再生障礙性貧血的分子生物學病理機制。

